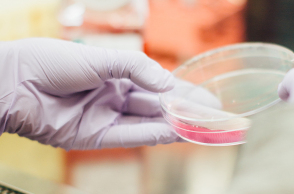
drew-hays-tgyrlchfobe-unsplash.jpg

- CITY GUIDE
- PODCAST
-
 17°
17°
Οι εξελίξεις στη θεραπεία του κορωνοϊού
«Η πίεση για θεραπεία και προφύλαξη δεν πρέπει να θέσει σε κίνδυνο την ασφάλεια και αποτελεσματικότητα των μελλοντικών φαρμάκων και εμβολίων»

Ο Αχιλλέας Γραβάνης, καθηγητής Φαρμακολογίας και Ερευνητής στο Ινστιτούτο Μοριακής Βιολογίας και Βιοτεχνολογίας του ΙΤΕ, αναλύει στην Athens Voice τις εξελίξεις στη θεραπεία του κορωνοϊού.
Πέντε μήνες μετά την εμφάνιση της λοίμωξης, προφανώς δεν έχουμε ακόμη αποτελεσματικό φάρμακο ή εμβόλιο, εκτός από τη Ρεμδεσιβίρη που έλαβε άδεια χορήγησής έκτακτης ανάγκης (EUA) από το FDA την 1η Μαΐου 2020, με βάση προκαταρκτικά στοιχεία που δείχνουν ταχύτερο χρόνο ανάρρωσης των εντός νοσοκομείου ασθενών με σοβαρή νόσο. Όμως, η αναζήτηση φαρμάκων και εμβολίων είναι καταιγιστική. Πολλοί αντιικοί παράγοντες, ανοσοθεραπείες και εμβόλια διερευνώνται πειραματικά αλλά ήδη μερικά και κλινικά. Σήμερα διενεργούνται διεθνώς περισσότερες από 500 κλινικές μελέτες για την εύρεση θεραπειών και 90 για την ανάπτυξη εμβολίων. Εντούτοις, η αναζήτηση αποτελεσματικών θεραπειών για τη λοίμωξη COVID-19 είναι μια πολύπλοκη διαδικασία και στα πρώτα της, όμως ταχύτατα βήματα.
Η επείγουσα ανάγκη για θεραπείες και η εύλογη πίεση των πολιτών και της πολιτείας κατά τη διάρκεια μιας πανδημίας μπορεί να οδηγήσει στη βιαστική και λανθασμένη ερμηνεία των κλινικών αποτελεσμάτων μιας πειραματικής θεραπείας, εάν η κλινική μελέτη δεν είναι σωστά σχεδιασμένη και τα δεδομένα της μελέτης δεν συλλέγονται και δεν αξιολογούνται προσεκτικά. Η πρώιμη πρόσβαση σε μη κλινικά αποδεδειγμένα αποτελεσματικά φάρμακα μπορεί να καθυστερήσει την εφαρμογή των αναγκαίων τυχαιοποιημένων ελεγχόμενων κλινικών δοκιμών και τελικά στην καθυστέρηση ανάπτυξης εμπεριστατωμένα αποτελεσματικών φαρμάκων. Στις παρακάτω παραγράφους παραθέτουμε τις σημαντικότερες από τις προσπάθειες της διεθνούς επιστημονικής κοινότητας στον δύσκολο και επίπονο δρόμο για την ανάπτυξη των τόσο αναγκαίων για τη λοίμωξη φαρμάκων και εμβολίων.
ΑΝΤΙΙΚΑ ΦΑΡΜΑΚΑ
Δεν έχουμε ακόμη αποτελεσματικά αντιικά φάρμακα. Χρειαζόμαστε περισσότερη έρευνα και κλινική αξιολόγηση για αποτελεσματικά αντιικά μικρά μόρια κατά του ιού SARS-CoV-2. Σήμερα, μόνο η ενδοφλέβια χορήγηση της ρεμδεσιβίρης βοηθά σοβαρά πάσχοντες ασθενείς με Covid-19. Τα μελλοντικά συνθετικά ανάλογά της ή οι μεταβολίτες της μπορεί να αποδειχθούν πιο αποτελεσματικά από την ίδια σε πρώιμους, εκτός νοσοκομείου ασθενείς, απαιτείται όμως η ανάπτυξη μορφών τους που χορηγούνται από το στόμα ή ενδομυϊκά και όχι μόνο ενδοφλέβια. Τα πρόσφατα ερευνητικά δεδομένα κρυσταλλογραφίας για τη χημική δομή των ενζύμων της πολυμεράσης και της πρωτεάσης του ιου SARS-CoV-2 που οδηγούν τον πολλαπλασιασμό του στους ασθενείς, η εφαρμογή υπολογιστικών τεχνολογιών (molecular dynamics, artificial intelligence) διευκολύνουν ήδη την in silico αξιολόγηση μεγάλων χημικών βιβλιοθηκών ήδη γνωστών για άλλες νόσους φαρμάκων (repurposing), αλλά και τον σχεδιασμό και την σύνθεση εξειδικευμένων για τον κορωνοϊό νέων αντιικών φαρμάκων. Οι προσπάθειες αυτές εστιάζουν επίσης την ήδη γνωστή χημική δομή του κυτταρικού υποδοχέα του ιού SARS-CoV-2, της πρωτεΐνης ACE2, για την ανάπτυξη ουσιών που θα συνδέονται με αυτόν και θα αποκλείουν τη σύνδεση του κορωνοϊού και κατά συνέπεια τη μόλυνση των κυττάρων των ασθενών. Μερικά μόνο από τα πλέον προωθημένα στην κλινική αξιολόγηση τους αντιικά φάρμακα είναι τα κατωτέρω.
Ρεμδεσιβίρη
Ο αντιικός αυτός παράγοντας ευρέος φάσματος είναι ένα νουκλεοτιδικό ανάλογο. Την 1η Μαΐου 2020, η FDA των ΗΠΑ έδωσε την άδεια για τη χορήγησή της σε επείγουσες καταστάσεις βαρέως πασχόντων ασθενών με σοβαρή Covid-19. Η ρεμδεσιβίρη μελετήθηκε σε κλινικές δοκιμές για τον ιό Έμπολα, αλλά απεδείχθη αναποτελεσματική. Έχει δειχθεί ότι αναστέλλει τον πολλαπλασιασμό των SARS-CoV, MERS-CoV σε ζωικά μοντέλα. Πολλαπλές κλινικές δοκιμές φάσης 3 δοκιμάζουν τη ρεμδεσιβίρη για τη θεραπεία του COVID-19 στις Ηνωμένες Πολιτείες, τη Νότια Κορέα, την Ευρώπη και την Κίνα. Μια τυχαιοποιημένη κλινική μελέτη της ρεμδεσιβίρης που συντονίστηκε από το Εθνικά Ινστιτούτα Υγείας (ΝΙΗ) των ΗΠΑ ξεκίνησε ως πρώτη μελέτη με σύγκριση με εικονικό φάρμακο. Οι κλινικές δοκιμές της ρεμδεσιβίρης στη μέτρια και σοβαρή Covid-19 συνεχίζονται. Τα προκαταρκτικά αποτελέσματα δείχνουν ότι οι ασθενείς που έλαβαν το φάρμακο είχαν 31% γρηγορότερο χρόνο ανάρρωσης από εκείνους που έλαβαν εικονικό φάρμακο (11 ημέρες σε ασθενείς σε σύγκριση με 15 ημέρες με εικονικό φάρμακο). Τα αποτελέσματα έδειξαν επίσης ένα όφελος στην επιβίωση 7,1% στην ομάδα του φαρμάκου, σε σύγκριση με το 11,9% στην ομάδα του εικονικού φαρμάκου, αλλά η διαφορά αυτή δεν ήταν στατιστικά σημαντική.
Λοπιναβίρη / ριτοναβίρη
Είναι αντιικά φάρμακα κατά του ιού του AIDS. Σε τυχαιοποιημένη, ελεγχόμενη κλινική δοκιμή σε νοσηλευόμενους με SARS-CoV-2 ασθενείς, η κλινική βελτίωση δεν διέφερε μεταξύ της τυπικής ομάδας φροντίδας. Το ποσοστό θνησιμότητας στις 28 ημέρες ήταν αριθμητικά χαμηλότερο για τη λοπιναβίρη / ριτοναβίρη σε σύγκριση με την τυπική περίθαλψη (19,2% έναντι 25%) αλλά δεν ήταν στατιστικά σημαντική. Μελέτες με συγχορήγηση με την ιντερφερόνη έχουν ξεκινήσει σε Αμερική και Ευρώπη.
EIDD-2801
Από του στόματος βιοδιαθέσιμο νέο αντιικό φάρμακο ευρέος φάσματος που αναπτύχθηκε στο πανεπιστήμιο Emory των ΗΠΑ. Όταν χορηγήθηκε τόσο προφυλακτικά όσο και θεραπευτικά σε πειραματόζωα μολυσμένα με τον SARS-CoV-2, βελτίωσε την πνευμονική λειτουργία και μείωσε τον τίτλο του κορωνοϊού και την κακουχία και απώλεια σωματικού βάρους. Ανακοινώθηκε ότι οι κλινικές δοκιμές θα μετακινηθούν σύντομα στους ανθρώπους. Η χορήγησή του από το στόμα είναι σημαντικό του πλεονέκτημα.
Φαβιπιραβίρη
Από του στόματος αντιικό φάρμακο εγκεκριμένο για τη θεραπεία της γρίπης στην Ιαπωνία. Αναστέλλει αποτελεσματικά την πολυμεράση του κορωνοϊού. Η Ιαπωνία ξεκίνησε κλινική δοκιμή φάσης 3. Στις Ηνωμένες Πολιτείες, κλινική δοκιμή φάσης 2 θα εγγράψει περίπου 50 ασθενείς με COVID-19. Στην Ινδία, ξεκίνησε τον Μάιο του 2020 κλινική δοκιμή φάσης 3.
ΜΟΝΟΚΛΩΝΙΚΑ ΑΝΤΙΣΩΜΑΤΑ
Το πλάσμα από ασθενείς που έχουν ανανήψει μετά τη λοίμωξη με τον ιό SARS-CoV-2 είναι η πηγή για την ιδέα της παραγωγής αντισωμάτων κατά των πρωτεϊνών του κορωνοϊού, που τον αδρανοποιούν δρώντας ως αντιικά φάρμακα. Η απομόνωση, ο χημικός χαρακτηρισμός και η παραγωγή ανασυνδυασμένου DNA για τα συγκεκριμένα αντισώματα οδήγησαν σε αντιικές πρωτεΐνες-αντισώματα κατά του SARS-CoV-2, συγκεκριμένα κατά της πρωτεΐνης S και των πρωτεϊνών του NSPs. Πειραματόζωα με εξανθρωπισμένο ανοσοποιητικό σύστημα χρησιμοποιούνται για την ανοσοποίηση και παραγωγή ανθρώπινων ιικών μονοκλωνικών αντισωμάτων κατά του κορωνοϊού. Μίγματα αυτών των μονοκλωνικών αντισωμάτων κατά των ιικών πρωτεϊνών του SARS-Cov-2 είναι πιθανόν να αποτελέσουν μέχρι τέλος του χρόνου την πρώτη αποτελεσματική αντιική θεραπεία. Τα πλέον προωθημένα όσον αφορά την προκλινική και κλινική μελέτης τους είναι τα κατωτέρω:
Αντι-SARS-CoV-2 πολυκλωνική υπερανοσοσφαιρίνη (Takeda)
Υπό ανάπτυξη για τη θεραπεία ασθενών υψηλού κινδύνου. Συμπυκνωμένα ειδικά για τον κορωνοϊό αντισώματα από πλάσμα που συλλέγονται από άτομα που έχουν ήδη αναρρώσει από το COVID-19.
Μονοκλωνικά αντισώματα (Regeneron)
Μείγμα μονοκλωνικών αντισωμάτων κατά διαφόρων περιοχών της πρωτεΐνης S του κορωνοϊού που ξεκινά τις κλινικές δοκιμές τον Ιούνιο του 2020.
Αντισώματα κατά του κορωνοϊού (Eli Lilly & AbCellera)
Θεραπεία αντισωμάτων από περισσότερα από 500 μονοκλωνικά αντισώματα που απομονώθηκαν από έναν από τους πρώτους ασθενείς των ΗΠΑ που ανένηψε από την COVID-19.
Αντισώματα κατά του κορωνοϊού (Amgen & Adaptive Biotechnologies)
Ανακάλυψη / ανάπτυξη πλήρως ανθρώπινων εξουδετερωτικών αντισωμάτων που στοχεύουν τον ιο SARS-CoV-2.
COVI-SHIELD (Sorento Therapeutics)
Ανάπτυξη μείγματος μονοκλωνικών αντισωμάτων κατά του κορωνοϊού σε συνεργασία με το νοσοκομείο Mt Sinai της Νέας Υόρκης.
ΕΜΒΟΛΙΑ
Το γονιδίωμα του ιού SARS-CoV-2 δημοσιεύθηκε στις 11 Ιανουαρίου 2020. Η ταχεία πρόοδος της έρευνας και της συνεργασίας μεταξύ επιστημόνων και φαρμακευτικών και βιοτεχνολογικών εταιριών που ακολούθησε έχει ήδη αποδώσει σχεδόν 90 επιβεβαιωμένα δραστικά στην προκλινική αξιολόγηση πιθανά εμβόλια. Χρησιμοποιούνται ήδη διάφορες νέες μέθοδοι για την ανακάλυψη και την παρασκευή εμβολίων κατά του κορωνοϊού. Εκτός από την πολυπλοκότητα της εύρεσης των πιο αποτελεσματικών υποψηφίων εμβολίων, η διαδικασία κατασκευής τους είναι επίσης σημαντική για την παραγωγή τους στην τεράστια κλίμακα που απαιτείται παγκοσμίως, για την κάλυψη του παγκόσμιου πληθυσμού. Βιοτεχνολογικές τεχνολογίες που βασίζονται σε DNA ή mRNA πλατφόρμες που προσφέρουν περισσότερη ευελιξία σε σύγκριση με εξουδετερωμένα ιικά σωματίδια ή τον χειρισμό πρωτεϊνών-αντιγόνων θα επιταχύνουν την ανάπτυξη των εμβολίων κατά του κορωνοϊού. Η παραγωγή τους με βάση ανασυνδυασμένες πρωτεΐνες μπορεί να αποδειχθεί ευεργετική λόγω των δυνατοτήτων παραγωγής μεγάλης κλίμακας που προσφέρουν αυτές οι νέες στην παραγωγή εμβολίων τεχνολογίες. Ωστόσο, αυτές οι τεχνολογίες δεν έχουν ακόμη αποδώσει ένα επιτυχημένο εμβόλιο.
Η χρήση ανοσοενισχυτικών ουσιών των εμβολίων (adjuvants) έχει ιδιαίτερη σημασία σε μια πανδημία. Τα adjuvants αυτά είναι ουσίες που ενισχύουν το αντιγόνο του εμβολίου, μειώνοντας έτσι την ποσότητα της πρωτεΐνης αντιγόνου που απαιτείται ανά χορήγηση στο άτομο που εμβολιάζεται. Η τεχνολογία αυτή επιτρέπει να εμβολιάσουμε περισσότερα άτομα και να εξοικονομήσουμε ποσότητες του τόσο σημαντικού για την παραγωγή του εμβολίου ιικού αντιγόνου.Τα έξι πιο προηγμένα εμβόλια στην κλινική τους αξιολόγηση είναι τα ακόλουθα:
mRNA-1273 (Moderna Inc & NIAID-NIH)
Η μελέτη φάσης 1 ξεκίνησε σε 45 υγιείς εθελοντές τον Μάρτιο του 2020, ενώ η κλινική μελέτη φάσης 2 τον Μάιο του 2020, συγκρίνοντας το εικονικό φάρμακο με το εμβόλιο σε 600 εθελοντές. Η κλινική μελέτη φάσης 3 έχει προγραμματιστεί για τον Ιούλιο του 2020, με την συμμετοχή 30.000 εθελοντών.
INO-4800, εμβόλιο DNA (Inovio Pharmaceuticals)
Η κλινική δοκιμή φάσης 1 στην οποία συμμετέχουν 40 υγιείς εθελοντές ολοκληρώθηκε τον Απρίλιο του 2020. Τα αποτελέσματα της ασφάλειας χορήγησης και της ανοσογονικότητας αναμένονται τον Ιούνιο.
Εμβόλιο mRNA BNT162 (BioNTech & Pfizer)
4 εμβόλια mRNA αναπτύσσονται παράλληλα, οι δοκιμές σε ανθρώπους άρχισαν τον Μάιο του 2020.
Εμβόλιο DNA ChAdOx1 nCoV-19 (Πανεπιστήμιο της Οξφόρδης & AstraZeneca)
Η φάση 1 ολοκληρώθηκε, οι κλινικές δοκιμές φάσης 2/3 ξεκίνησαν τον Μάιο του 2020 σε σημαντικό αριθμό εθελοντών.
SARS-CoV-2 εμβόλιο DNA (Johnson & Johnson)
Προϊόν συνεργασίας της J&J με την Emergent BioSolutions και την Catalent για την μαζική παραγωγή με την εφαρμογή των τεχνολογιών AdVac της J&J Janssen, για την εξασφάλιση της ταχείας μαζικής παραγωγής του εμβολίου.
Εμβόλιο με απενεργοποιημένο ιο SARS-CoV-2 (SinoVac)
Οι φάσεις 1, 2 σχεδόν ολοκληρώθηκαν με την συμμετοχή 1000 εθελοντών. Η φάση 3 της κλινικής αξιολόγησης ξεκινά τον Ιούνιο του 2020, με τη συμμετοχή πολλών δεκάδων χιλιάδων εθελοντών διαφόρων ηλικιών.
ΑΝΟΣΟΤΡΟΠΟΙΗΤΕΣ
Ένας άλλος θεραπευτικός στόχος είναι η ενίσχυση του ανοσοποιητικού συστήματος του ασθενούς ή ο έλεγχός του στις περιπτώσεις της παθολογικής υπεραντίδρασης του, της ανοσολογικής καταιγίδας. Δοκιμάστηκαν διάφορα γνωστά ήδη για άλλες νόσους φάρμακα, για τον έλεγχο της υπερφλεγμονής που οφείλεται στην απελευθέρωση κυτταροκινών. Αναστολείς της ιντερλευκίνης (IL) 6 και 1, αναστολείς του ενζύμου-κινάση Janus kinase (JNK) και οι ιντερφερόνες είναι μερικά μόνο από τα γνωστά φάρμακα που βρίσκονται ήδη σε κλινικές δοκιμές στη λοίμωξη του κορωνοϊού. Το από δεκαετίες γνωστό ανθελονοσιακό Χλωροκίνη ήταν από τα πρώτα φάρμακα που δοκιμάστηκαν με περιορισμένη όμως αποτελεσματικότητα, με αμφιλεγόμενα κλινικά δεδομένα και σημαντική καρδιοτοξικότητα που αμφισβητεί τη χρησιμότητά της. Τα βασικά τρία φάρμακα με ανοσοτροποποιητική δράση που έχουν δείξει ενθαρρυντικά αποτελέσματα είναι τα κατωτέρω:
Μονοκλωνικά αντισώματα κατά του κυτταρικού υποδοχέα της Ιντερλευκίνης 6 (Regeneron, Sanofi, Genentech)
Κλινικές μελέτες φάσης 2 σε ασθενείς με Covid-19 και σοβαρά πνευμονικά συμπτώματα έδειξαν υποσχόμενα αποτελέσματα, βελτιώνοντας τις ανάγκες των ασθενών σε οξυγόνο, ο αριθμός των λεμφοκυττάρων τους επανήλθε στο φυσιολογικό και 19 ασθενείς εξήλθαν από την ΜΕΘ 15 ημέρες μετά τη θεραπεία. Μεγάλες διπλές τυφλές μελέτες φάσης 2/3, στις οποίες συμμετέχουν χιλιάδες ασθενείς, βρίσκονται σε εξέλιξη στις ΗΠΑ, την Ευρώπη και την Ασία για την αξιολόγηση της αποτελεσματικότητάς της για την προστασία των νοσηλευόμενων σε νοσοκομείο ασθενών. Τα αποτελέσματα αναμένονται τον Ιούλιο-Αύγουστο 2020.
Βαρισιτινίδη (Eli Lilly) ρουξολιτινίβη (Incyte)
Φάρμακα που στοχεύουν την κινάση Janus κινάσης (JNK) που σηματοδοτεί τη φλεγμονή μπορούν να μετριάσουν τη συστηματική και κυψελιδική φλεγμονή σε ασθενείς με πνευμονία COVID-19, αναστέλλοντας την κυτταρική σηματοδότηση των κυτταροκινών, που εμπλέκονται στην φλεγμονώδη απόκριση που προκαλείται από το ανοσοποιητικό. Οι αναστολείς αυτοί της JNK, εξετάζονται πλέον σε μεγάλες τυχαιοποιημένες ελεγχόμενες κλινικές μελέτες φάσης 2.
Ραβουλιζουμάμπη (Alexion)
Τυχαιοποιημένη ελεγχόμενη δοκιμή φάσης 3 σχεδιάστηκε σε νοσηλευόμενους ενήλικες με σοβαρή πνευμονία για την αξιολόγηση της αναστολής του συμπληρώματος (C5) ως θεραπεία. Η κλινική δοκιμή στηρίχθηκε σε προκλινικά δεδομένα από ζωικά μοντέλων που υποδηλώνουν ότι η αναστολή του συμπληρώματος C5 μειώνει τα επίπεδα των προφλεγμονωδών κυτταροκινών, μειώνοντας τη φλεγμονή των πνευμόνων.
ΑΝΤΙΠΗΚΤΙΚΑ-ΑΝΤΙΘΡΟΜΒΩΤΙΚΑ
Τα πρόσφατα κλινικά δεδομένα δείχνουν ότι ο κορωνοϊός προσβάλλει έντονα το αγγειακό σύστημα. Πράγματι, τα ενδοθηλιακά κύτταρα στον μέσα χιτώνα των αγγείων εκφράζουν τον κυτταρικό υποδοχέα ACE2 και μολύνονται από τον ιό. Η σοβαρή νόσος Covid-19 εκδηλώνεται με προβλήματα στην πήξη του αίματος μέσα στους πνεύμονες αλλά και γενικά μπορεί να εξελιχθεί σε διάχυτη ενδοαγγειακή πήξη, φλεβική θρομβοεμβολή ή αρτηριακή θρόμβωση. Οι προδιαθεσικοί παράγοντες κινδύνου για σοβαρό Covid-19 είναι οι υποκείμενες καρδιαγγειακές παθήσεις ή οι καρδιαγγειακοί παράγοντες κινδύνου συμπεριλαμβανομένου του μη ελεγχόμενου διαβήτη ή υπέρτασης, της παχυσαρκίας. Οι ασθενείς με αγγειακές νόσους είναι η πιο σημαντική ομάδα-στόχος για την εστίαση των προσπαθειών. Για τους νοσηλευόμενους ασθενείς με Covid-19, η ηπαρίνη χαμηλού μοριακού βάρους (LMWH) είναι το φάρμακο επιλογής για την προφύλαξη και τη θεραπεία προβλημάτων πήξης και για τη θεραπεία της υπερπηκτικότητας. Προτείνεται επίσης η παρακολούθηση των D-dimers για τη βελτιστοποίηση της αντιθρομβωτικής θεραπείας. Προληπτική χορήγηση της LMWH ή της ριβαροξαμπάνης προτείνεται πλέον για την πρόληψη φλεβικής θρομβοεμβολής σε ασθενείς με υψηλό κίνδυνο Covid-19 που υποβάλλονται σε θεραπεία στο σπίτι καθώς και σε ασθενείς υψηλού κινδύνου για φλεβική θρομβοεμβολή μετά την έξοδό τους από το νοσοκομείο. Ο έλεγχος των καρδιαγγειακών παραγόντων κινδύνου αποτελεί πλέον θεμελιώδη θεραπευτική στρατηγική για ασθενείς με COVID-19. Και έχει βελτιώσει σημαντικά την αντιμετώπιση της λοίμωξης.
ΣΥΜΠΕΡΑΣΜΑΤΑ
Χρειαζόμαστε περισσότερη έρευνα και κλινική αξιολόγηση για την ανάπτυξη αποτελεσματικών αντιικών μικρών μορίων κατά του ιού SARS-CoV-2. Σήμερα, μόνο η ενδοφλέβια χορήγηση της ρεμδεσιβίρης βοηθά οριακά τους σοβαρά πάσχοντες ασθενείς με Covid19. Νέα συνθετικά ανάλογα ή οι μεταβολίτες της ρεμδεσιβίρης ίσως αποδειχθούν πιο αποτελεσματικά φάρμακα σε περιπατητικούς ασθενείς στα πρώιμα στάδια της νόσου, με την προοπτική να υπάρξουν σε φαρμακευτικές μορφές από του στόματος ή ενδομυϊκής χορήγησης.
Τα πρώτα αποτελεσματικά αντιικά φάρμακα κατά του SARS-CoV-2 ίσως να αποδειχθούν τα μονοκλωνικά αντισώματα κατά των ιικών πρωτεϊνών. Πολλές προγραμματισμένες ήδη κλινικές δοκιμές ενδέχεται να τα προσφέρουν έως το τέλος του 2020.
Το γονιδίωμα του ιού SARS-CoV-2 είναι μάλλον σταθερό (τουλάχιστον εξίσου σταθερό με τον ιό της γρίπης). Είναι πλέον σαφές ότι οι ασθενείς που έχουν προσβληθεί από τον SARS-CoV-2 αναπτύσσουν αντισώματα, δεν γνωρίζουμε όμως ακόμα για πόσο χρόνο μετά τη λοίμωξη αυτά συνεχίζουν να παράγονται. Αποτελεσματικά, μη τοξικά εμβόλια μάλλον να έρθουν το επόμενο καλοκαίρι. Οι νέες τεχνολογίες (εμβόλια DNA, RNA) θα εξασφαλίσουν τη ταχύτερη μαζική παραγωγή τους.
Η πρόοδος στις συμπτωματικές θεραπείες, με τον αποτελεσματικότερο έλεγχο στους βαρέως πάσχοντες των επιδράσεων του SARS-CoV-2 στη φλεγμονή-ανοσολογική καταιγίδα στους πνεύμονες, στην πήξη του αίματος-θρόμβωση, στην καρδιακή λειτουργία βοηθά σήμερα πολλούς ασθενείς με σοβαρή ασθένεια Covid19. Ο συνδυασμός των συμπτωματικών θεραπειών με τα επικείμενα αντιικά φάρμακα, η εξατομίκευση της θεραπευτικής αγωγής ανάλογα με το στάδιο της νόσου και τον τύπο του ασθενούς θα βελτιώσει σημαντικά τη θεραπεία.
Η πίεση για θεραπεία και προφύλαξη από τον πανδημικό ιό SARS-CoV-2 δεν πρέπει να θέσει σε κίνδυνο την ασφάλεια και την αποτελεσματικότητα των μελλοντικών φαρμάκων και εμβολίων. Γι’ αυτό, απαιτούνται καλά σχεδιασμένες, τυχαιοποιημένες με ομάδα ελέγχου κλινικές μελέτες για την αποφυγή αστοχιών.
*Ο Αχ. Γρ. είναι καθηγητής Φαρμακολογίας στην Ιατρική Σχολή του Πανεπιστημίου Κρήτης και Ερευνητής στο Ινστιτούτο Μοριακής Βιολογίας και Βιοτεχνολογίας του ΙΤΕ
ΤΑ ΠΙΟ ΔΗΜΟΦΙΛΗ

ΔΙΑΒΑΖΟΝΤΑΙ ΠΑΝΤΑ
ΔΕΙΤΕ ΕΠΙΣΗΣ
Τι πρέπει να αλλάξετε την επόμενη φορά που θα γυρίσετε από το σούπερ μάρκετ
Η σύνδεση με τις ημικρανίες, ποιοι είναι πιο επιρρεπείς
Δεν οφείλεται μόνο στη στάση ύπνου - Συνδέεται άμεσα με την ικανότητα του ανθρώπου να μιλά
Ποιους αφορά, πότε θα είναι διαθέσιμo
Το 38% του ενήλικου πληθυσμού είναι χρήστες καπνικών προϊόντων
Οι επιστήμονες χρησιμοποιούν τον όρο «υψηλός πνευμονογαστρικός τόνος»
Η σημασία της διατροφής και της άσκησης
Νάρθηκες, φυσικοθεραπεία και η επιλογή της επέμβασης
Πώς η απλή καταγραφή των σκέψεων και των συναισθημάτων μας θωρακίζει απέναντι στο στρες
Η περίπτωση ενός άντρα που υπέστη σπάνια αλλεργική αντίδραση
Όταν η κούραση είναι κάτι περισσότερο από ανθρώπινη κατάσταση
Φυσικά η τεχνολογία δεν μπορεί να αντικαταστήσει την ανθρώπινη φροντίδα
Έρευνες δείχνουν ότι περίπου 1 στους 4 δεν εμφανίζει καθόλου συμπτώματα, ακόμη και μετά από βαριά κατανάλωση αλκοόλ
Η επαφή με το περιβάλλον μειώνει άμεσα το στρες, ρυθμίζει ορμόνες, ενισχύει το ανοσοποιητικό και βελτιώνει τη διάθεση
Οι τεχνικές που ηρεμούν το σώμα και τον νου όταν οι αρνητικές σκέψεις κυριαρχούν στην καθημερινότητα
Η κλινική δοκιμή περιέλαβε περισσότερους από 4.400 ασθενείς
Η δημοφιλής μέθοδος δροσιάς που τελικά χαλάει τον ύπνο - Πώς να τον χρησιμοποιήσετε σωστά
Eιδικοί εξηγούν γιατί το βάδισμα είναι το θεμέλιο της ευεξίας και πώς προστατεύει σώμα και πνεύμα
Επιστήμονες ανακάλυψαν ότι τα έντομα συνδέουν τη μυρωδιά του DEET με την τροφή, ανατρέποντας όσα ξέραμε
Με επίκεντρο το μέλλον της ογκολογικής φροντίδας
Έχετε δει 20 από 200 άρθρα.